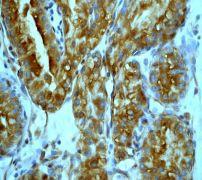

> Antigen, Antibodies, ELISA, Western Blot > Primary Antibody > Monoclonal Antibodies > FKHR AntibodyBrand |
Leading Biology | Catalog Number |
AMM04563G |
Product Type |
Monoclonal Antibodies | Field of Research |
|
Product Overview |
We constantly strive to ensure we provide our customers with the best antibodies. As a result of this work we offer this antibody in purified format.
We are in the process of updating our datasheets. If you have any questions regarding this update, please feel free to contact our technical support team.
This product is a high quality FKHR antibody.
|
||
Molecular Weight |
69662 Da
|
||
Cellular Localization |
Antigen Cellular Localization:
Cytoplasm {ECO:0000250|UniProtKB:Q9R1E0}. Nucleus {ECO:0000250|UniProtKB:Q9R1E0}. Note=Shuttles between the cytoplasm and nucleus. Largely nuclear in unstimulated cells. In osteoblasts, colocalizes with ATF4 and RUNX2 in the nucleus (By similarity). Insulin-induced phosphorylation at Ser-256 by PKB/AKT1 leads, via stimulation of Thr-24 phosphorylation, to binding of 14-3-3 proteins and nuclear export to the cytoplasm where it is degraded by the ubiquitin-proteosomal pathway Phosphorylation at Ser-249 by CDK1 disrupts binding of 14-3-3 proteins and promotes nuclear accumulation. Phosphorylation by NLK results in nuclear export. Translocates to the nucleus upon oxidative stress-induced phosphorylation at Ser-212 by STK4/MST1 SGK1-mediated phosphorylation also results in nuclear translocation. Retained in the nucleus under stress stimuli including oxidative stress, nutrient deprivation or nitric oxide Retained in the nucleus on methylation.
|
||
Host |
Rabbit
|
||
Species Reactivity |
Human, Mouse, Rat
|
||
Target |
A synthetic peptide corresponding to residues surrounding Ser329 of human FKHR was used as immunogen. Anti-FKHR RabMab recognizes both phosphorylated and unphosphorylated FKHR.
|
||
Clone |
EP927Y
|
||
Symbol |
FKHR, FOXO1A
|
||
GeneID |
|||
UniProt ID |
|||
Function |
Transcription factor that is the main target of insulin signaling and regulates metabolic homeostasis in response to oxidative stress. Binds to the insulin response element (IRE) with consensus sequence 5'-TT[G/A]TTTTG-3' and the related Daf-16 family binding element (DBE) with consensus sequence 5'- TT[G/A]TTTAC-3'. Activity suppressed by insulin. Main regulator of redox balance and osteoblast numbers and controls bone mass. Orchestrates the endocrine function of the skeleton in regulating glucose metabolism. Acts synergistically with ATF4 to suppress osteocalcin/BGLAP activity, increasing glucose levels and triggering glucose intolerance and insulin insensitivity. Also suppresses the transcriptional activity of RUNX2, an upstream activator of osteocalcin/BGLAP. In hepatocytes, promotes gluconeogenesis by acting together with PPARGC1A to activate the expression of genes such as IGFBP1, G6PC and PPCK1. Important regulator of cell death acting downstream of CDK1, PKB/AKT1 and SKT4/MST1. Promotes neural cell death. Mediates insulin action on adipose. Regulates the expression of adipogenic genes such as PPARG during preadipocyte differentiation and, adipocyte size and adipose tissue-specific gene expression in response to excessive calorie intake. Regulates the transcriptional activity of GADD45A and repair of nitric oxide-damaged DNA in beta-cells. Required for the autophagic cell death induction in response to starvation or oxidative stress in a transcription-independent manner.
|
||
Summary |
FKHR (FoxO1), a member of the FoxO subfamily of forkhead transcription factors, is an important target for insulin and growth factor signaling in the regulation of metabolism, cell cycle and proliferation, and survival in peripheral tissues (1). FKHR is regulated by insulin via Akt-dependent phosphorylation and nuclear exclusion. It has been shown that FoxO1 is induced in the early stages of adipocyte differentiation but that its activation is delayed until the end of the clonal expansion phase. Constitutively active FoxO1 prevents the differentiation of preadipocytes, while dominant-negative Foxo1 restores adipocyte differentiation of fibroblasts from insulin receptor-deficient mice (2). Conserved residue (Ser329) is a novel in-vivo phosphorylation site on FKHR. Phosphorylation of this site also decreases the ability of FKHR to stimulate gene transactivation and reduces the proportion of FKHR present in the nucleus (3)
|
||
Form |
50 mM Tris-Glycine (pH 7.4), 0.15 M NaCl, 40% Glycerol, 0.01% sodium azide and 0.05% BSA. |
||
Storage & Stability |
Store at +4°C short term. For long-term storage, aliquot and store at -20°C or below. Stable for 12 months at -20°C. Avoid repeated freeze-thaw cycles.
|
||
Applications |
WB, IHC, IF
|
||
Dilution |
WB~~1:500~1000
IHC~~1:250~500
|
||
Synonyms |
Forkhead box protein O1, Forkhead box protein O1A, Forkhead in rhabdomyosarcoma, FOXO1, FKHR, FOXO1A
|
||
Images |

A. Western blot analysis on NIH/3T3 cell lysate using anti-FKHR RabMAb (Cat. AMM04563G), dilution 1:1000
B. Immunohistochemical staining of paraffin-embedded human bladder carcinoma using anti-FKHR RabMAb (Cat. AMM04563G). 
C. Immunofluorescent staining of HeLa cells using anti-FKHR RabMAb (Cat. AMM04563G). |
||
Specification |
|||
Quantity |
|
||
| Select | Brand | Catalog No. | Product Name | Pack Size | Type | Field of Research | Specification | Quantity | Price(USD) | |
| 1 | Leading Biology | APG02467G | CCK4 / PTK7 Antibody (clone 4F9) | 50 μl | Monoclonal Antibodies |
|
$495.00 | Add Ask | ||
| 2 | Leading Biology | AMM04683G | GALT Antibody (clone 4C11) | 50 μg | Monoclonal Antibodies |
|
$545.00 | Add Ask | ||
| 3 | Leading Biology | AMM01402G | Vimentin (Mesenchymal Cell Marker) Antibody - With BSA and Azide | 50 ug | Monoclonal Antibodies |
|
$395.00 | Add Ask | ||
| 4 | Leading Biology | APR08280G | LTA4H / LTA4 Antibody (clone 9G8) | 50 μl | Monoclonal Antibodies |
|
$495.00 | Add Ask | ||
| 5 | Leading Biology | AMM00172G | CD1a / HTA1 (Mature Langerhans Cells Marker) Antibody - With BSA and Azide | 50 ug | Monoclonal Antibodies |
|
$395.00 | Add Ask | ||
| 6 | Leading Biology | AMM05750G | CEBPA Antibody | 100 μl | Monoclonal Antibodies |
|
$545.00 | Add Ask |
 Leading Biology Inc.
2600 Hilltop DR, Building G, B Suite C138
Richmond, CA, 94806
Tel: 1-661-524(LBI)-0262
Email: info@leadingbiology.com
Leading Biology Inc.
2600 Hilltop DR, Building G, B Suite C138
Richmond, CA, 94806
Tel: 1-661-524(LBI)-0262
Email: info@leadingbiology.com
Complete this form and click send to ask us a question, request a quote or simply say hello.

You have 0 item in your cart

You have 0 item in your inquiry list
